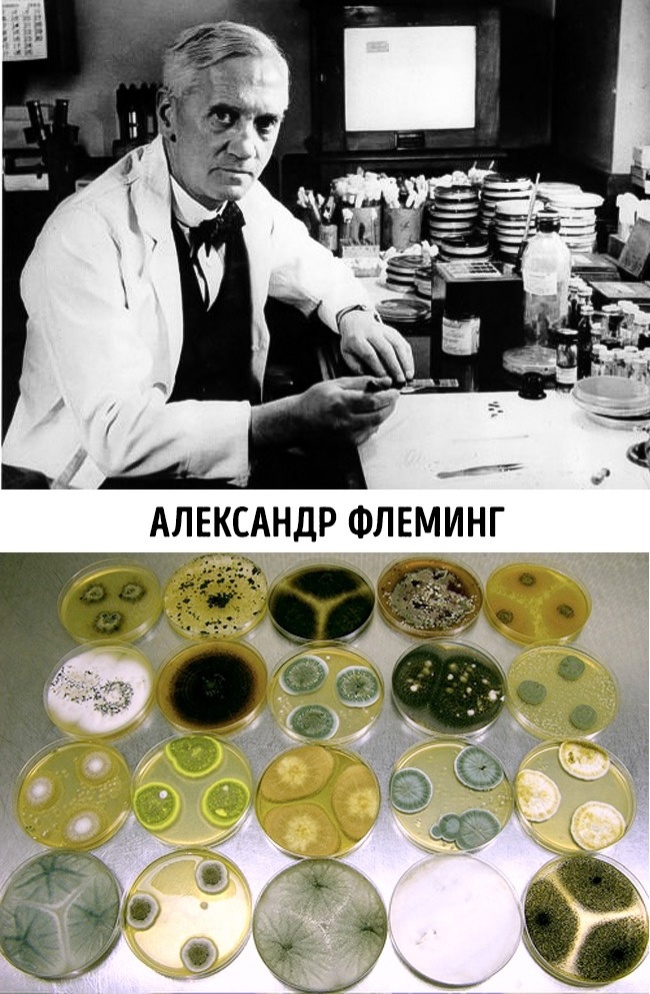
9 нелепых случайностей, которые изменили ход истории 9 нелепых случайностей, которые изменили ход истории

9 нелепых случайностей, которые изменили ход истории
Так или иначе все в мире построено на случайностях. Наверняка каждый из нас может найти подтверждение этой мысли и в собственной жизни.
Метеорит и христианство

События, которые описываются как «путь в Дамаск», сыграли колоссальную роль в становлении христианства. И скорее всего, они связаны с падением метеорита.
Апостол Павел направлялся в Дамаск на поимку местных христиан. По дороге он увидел на небесах ярчайший свет, был сбит с ног ударной волной и услышал оглушительный грохот. Он ослеп на 3 дня и прозрел лишь в Дамаске, после встречи с христианином Ананией.
Произошедшее Павел растолковал как Божье знамение и стал активно проповедовать христианство.
Трудности перевода и атомная бомба

В 1945 года США потребовали от Японии капитуляции. В своем ответе японский премьер Судзуки использовал слово mokusatsu, которое можно перевести как «без комментариев», «остаемся в нейтральном молчании» или «мы подумаем».
При переводе это слово превратилось в «мы игнорируем», а потом по принципу глухого телефона в «мы отвергаем» и «мы рассматриваем ваш вопрос с презрением».
Такой ответ оскорбил президента США Трумэна, что подтолкнуло его сбросить на Японию пару атомных бомб.
«Титаник» и помощник капитана

Ключи от шкафа, где хранились бинокли команды «Титаника», могли бы спасти жизни всех, кто погиб в крушении лайнера. Если бы не Дэвид Блэр, получивший должность второго офицера на «Титанике» и отстраненный в последний момент перед роковым плаванием.
Уходя с парохода, Блэр забыл выложить из кармана ключи от шкафчика с биноклями. Поэтому часть экипажа была лишена возможности увидеть тот самый айсберг до того, как произошло непоправимое.
Небрежность и пенициллин

Ученый Александр Флеминг не очень-то следил за порядком. Он забыл убраться в своей лаборатории, оставил стафилококки в чашке Петри и ушел в отпуск на 2 недели.
Все это время в лабораторию никто не входил, и когда Флеминг вернулся, перед ним предстала удивительная картина. Чашки были заполнены плесенью, а стафилококки умерли.
Так был открыт антибиотик пенициллин и люди перестали погибать от целого ряда бактериальных инфекций.
Падение Берлинской стены и рассеянность политика

В 1989 году восточногерманский политик Гюнтер Шабовски созвал пресс-конференцию, чтобы объяснить незначительные изменения в законе о пересечении Берлинской стены. В его речи проскользнул намек на то, что какие-либо ограничения по выездам будут вообще сняты. Журналист, услышавший именно такой подтекст, спросил, когда же изменения вступят в силу.
На это Шабовски сказал: «Немедленно». Пресса моментально напечатала о том, что запретов больше нет. Это повлекло за собой столпотворение людей у стены, которые требовали разрешения пройти. Власти, чтобы избежать бунта, позволили стене пасть.
Почему Шабовски ответил именно так? Вероятно, он просто все перепутал. Но он стал человеком, фактически разрушившим Берлинскую стену.
Неуклюжесть ученого и небьющееся стекло

В 1903 году ученый Эдуард Бенедиктус уронил на пол колбу. К его удивлению, она не разлетелась на осколки, а лишь растрескалась. Ученый вспомнил, что после предыдущего опыта на стенках колбы сохранился тонкий слой нитрата целлюлозы.
Бенедиктус сделал «бутерброд» из двух стекол, склеенных слоем нитрата целлюлозы. Такое стекло можно было бить молотком — оно трескалось, но не распадалось на осколки.
Так появилось стекло «триплекс», которое используется по сей день. Благодаря ему во время аварии водитель и пассажиры точно не погибнут от ранений осколками.
Наполеон и Франция

Личность и характер Наполеона во многом предрешили судьбу Франции. Этого могло бы не случиться, если бы не одно событие. Остров Корсика, где родился Наполеон, был передан Франции за долги по Компьенскому трактату всего за год до его рождения.
Именно это сделало его французом по рождению и дало возможность стать тем, кем он стал. Если бы остров остался во власти генуэзцев, скорее всего, Наполеон остался бы безвестным, хотя, как все мы знаем, история не терпит сослагательного наклонения.
Рентгеновские лучи

В 1895 году немецкий физик Вильгельм Рентген открыл новое излучение. Чтобы протестировать его свойства, он ставил на пути лучей разнообразные предметы. Совершенно случайно его рука попала в зону действия луча. То, что увидел ученый, шокировало его: он видел свою руку насквозь, а непрозрачными остались только кости.
Наблюдательность Рентгена полностью перевернула медицину, а Х-лучи были названы рентгеновскими в честь их первооткрывателя.
Константинополь и незапертые ворота

Константинополь выдерживал множество осад на протяжении тысячи лет, но пал в сражении с турками в 1453 году. Роковую роль при этом сыграла незапертая калитка Керкопорта.
Во всей системе укреплений Константинополя было несколько потайных ворот и калиток, которые могли быть использованы для разведывательных вылазок. Одна из них, по недосмотру (а может быть, умышленно?) была оставлена открытой после одной из таких вылазок. Через этот потайной вход армия турок спокойно вошла и захватила город.
Метеорит и христианство

События, которые описываются как «путь в Дамаск», сыграли колоссальную роль в становлении христианства. И скорее всего, они связаны с падением метеорита.
Апостол Павел направлялся в Дамаск на поимку местных христиан. По дороге он увидел на небесах ярчайший свет, был сбит с ног ударной волной и услышал оглушительный грохот. Он ослеп на 3 дня и прозрел лишь в Дамаске, после встречи с христианином Ананией.
Произошедшее Павел растолковал как Божье знамение и стал активно проповедовать христианство.
Трудности перевода и атомная бомба

В 1945 года США потребовали от Японии капитуляции. В своем ответе японский премьер Судзуки использовал слово mokusatsu, которое можно перевести как «без комментариев», «остаемся в нейтральном молчании» или «мы подумаем».
При переводе это слово превратилось в «мы игнорируем», а потом по принципу глухого телефона в «мы отвергаем» и «мы рассматриваем ваш вопрос с презрением».
Такой ответ оскорбил президента США Трумэна, что подтолкнуло его сбросить на Японию пару атомных бомб.
«Титаник» и помощник капитана

Ключи от шкафа, где хранились бинокли команды «Титаника», могли бы спасти жизни всех, кто погиб в крушении лайнера. Если бы не Дэвид Блэр, получивший должность второго офицера на «Титанике» и отстраненный в последний момент перед роковым плаванием.
Уходя с парохода, Блэр забыл выложить из кармана ключи от шкафчика с биноклями. Поэтому часть экипажа была лишена возможности увидеть тот самый айсберг до того, как произошло непоправимое.
Небрежность и пенициллин
Ученый Александр Флеминг не очень-то следил за порядком. Он забыл убраться в своей лаборатории, оставил стафилококки в чашке Петри и ушел в отпуск на 2 недели.
Все это время в лабораторию никто не входил, и когда Флеминг вернулся, перед ним предстала удивительная картина. Чашки были заполнены плесенью, а стафилококки умерли.
Так был открыт антибиотик пенициллин и люди перестали погибать от целого ряда бактериальных инфекций.
Падение Берлинской стены и рассеянность политика

В 1989 году восточногерманский политик Гюнтер Шабовски созвал пресс-конференцию, чтобы объяснить незначительные изменения в законе о пересечении Берлинской стены. В его речи проскользнул намек на то, что какие-либо ограничения по выездам будут вообще сняты. Журналист, услышавший именно такой подтекст, спросил, когда же изменения вступят в силу.
На это Шабовски сказал: «Немедленно». Пресса моментально напечатала о том, что запретов больше нет. Это повлекло за собой столпотворение людей у стены, которые требовали разрешения пройти. Власти, чтобы избежать бунта, позволили стене пасть.
Почему Шабовски ответил именно так? Вероятно, он просто все перепутал. Но он стал человеком, фактически разрушившим Берлинскую стену.
Неуклюжесть ученого и небьющееся стекло

В 1903 году ученый Эдуард Бенедиктус уронил на пол колбу. К его удивлению, она не разлетелась на осколки, а лишь растрескалась. Ученый вспомнил, что после предыдущего опыта на стенках колбы сохранился тонкий слой нитрата целлюлозы.
Бенедиктус сделал «бутерброд» из двух стекол, склеенных слоем нитрата целлюлозы. Такое стекло можно было бить молотком — оно трескалось, но не распадалось на осколки.
Так появилось стекло «триплекс», которое используется по сей день. Благодаря ему во время аварии водитель и пассажиры точно не погибнут от ранений осколками.
Наполеон и Франция

Личность и характер Наполеона во многом предрешили судьбу Франции. Этого могло бы не случиться, если бы не одно событие. Остров Корсика, где родился Наполеон, был передан Франции за долги по Компьенскому трактату всего за год до его рождения.
Именно это сделало его французом по рождению и дало возможность стать тем, кем он стал. Если бы остров остался во власти генуэзцев, скорее всего, Наполеон остался бы безвестным, хотя, как все мы знаем, история не терпит сослагательного наклонения.
Рентгеновские лучи

В 1895 году немецкий физик Вильгельм Рентген открыл новое излучение. Чтобы протестировать его свойства, он ставил на пути лучей разнообразные предметы. Совершенно случайно его рука попала в зону действия луча. То, что увидел ученый, шокировало его: он видел свою руку насквозь, а непрозрачными остались только кости.
Наблюдательность Рентгена полностью перевернула медицину, а Х-лучи были названы рентгеновскими в честь их первооткрывателя.
Константинополь и незапертые ворота

Константинополь выдерживал множество осад на протяжении тысячи лет, но пал в сражении с турками в 1453 году. Роковую роль при этом сыграла незапертая калитка Керкопорта.
Во всей системе укреплений Константинополя было несколько потайных ворот и калиток, которые могли быть использованы для разведывательных вылазок. Одна из них, по недосмотру (а может быть, умышленно?) была оставлена открытой после одной из таких вылазок. Через этот потайной вход армия турок спокойно вошла и захватила город.


Посетители, находящиеся в группе Гости, не могут оставлять комментарии к данной публикации.